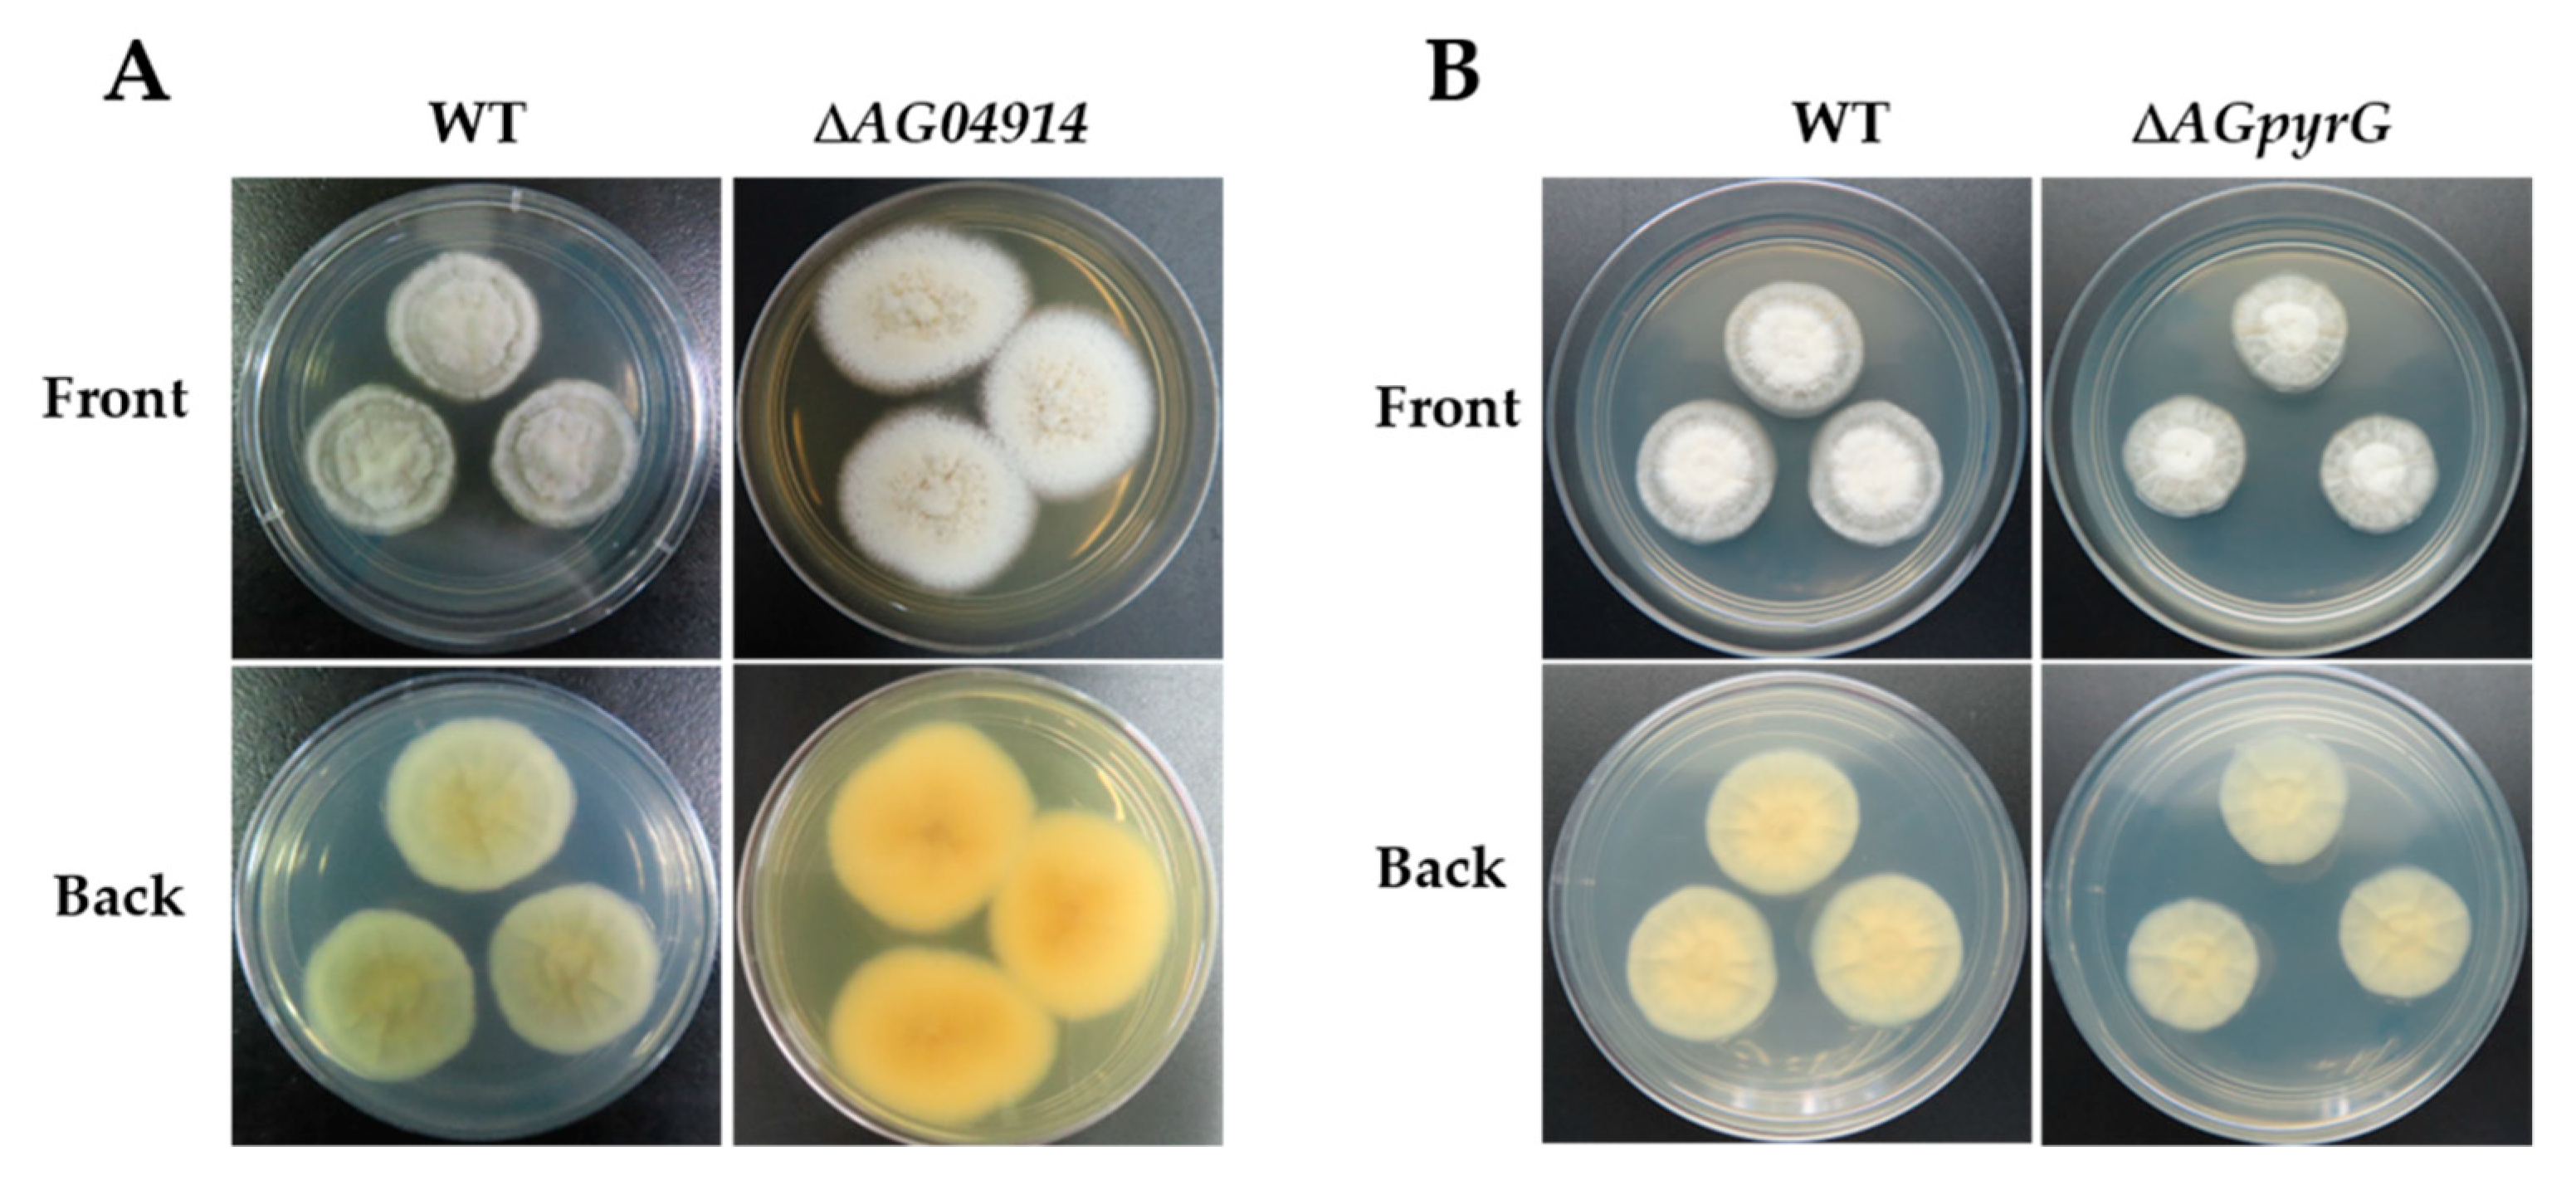
Jof 07 00138 g004 Jof 07 00138 g004

Establishment of a Genetic Transformation System in Guanophilic Fungus Amphichorda guana
Abstract
1. Introduction
2. Materials and Methods
2.1. Strains, Materials, and Culture Conditions
2.2. Maker Gene Selection and Fungal Sensitivity Test
2.3. Preparation of Protoplasts
2.4. Regeneration of Protoplasts
2.5. Construction of Deletion Cassettes
2.6. PEG-Mediated Protoplast Transformation
2.7. Verification of Transformants
3. Results
3.1. Maker Gene Selection and Fungal Sensitivity
3.2. Protoplast Preparation and Regeneration of Strain LC5815
3.3. PEG-Mediated Protoplast Transformation and Target Gene Deletion
4. Discussion
5. Conclusions
Supplementary Materials
Author Contributions
Funding
Institutional Review Board Statement
Data Availability Statement
Acknowledgments
Conflicts of Interest
References
- Ancheeva, E.; Daletos, G.; Proksch, P. Bioactive secondary metabolites from endophytic fungi. Curr. Med. Chem. 2020, 27, 1836–1854. [Google Scholar] [CrossRef]
- Xu, L.; Meng, W.; Cao, C.; Wang, J.; Shan, W.; Wang, Q. Antibacterial and antifungal compounds from marine fungi. Mar. Drugs 2015, 13, 3479–3513. [Google Scholar] [CrossRef]
- Bills, G.F.; Gloer, J.B.; An, Z. Coprophilous fungi: Antibiotic discovery and functions in an underexplored arena of microbial defensive mutualism. Curr. Opin. Microbiol. 2013, 16, 549–565. [Google Scholar] [CrossRef]
- Liu, J.; Liu, G. Analysis of secondary metabolites from plant endophytic fungi. Methods Mol. Biol. 2018, 1848, 25–38. [Google Scholar] [CrossRef]
- Habbu, P.; Warad, V.; Shastri, R.; Madagundi, S.; Kulkarni, V.H. Antimicrobial metabolites from marine microorganisms. Chin. J. Nat. Med. 2016, 14, 101–116. [Google Scholar] [CrossRef]
- Yan, L.; Zhao, H.; Zhao, X.; Xu, X.; Di, Y.; Jiang, C.; Shi, J.; Shao, D.; Huang, Q.; Yang, H.; et al. Production of bioproducts by endophytic fungi: Chemical ecology, biotechnological applications, bottlenecks, and solutions. Appl. Microbiol. Biotechnol. 2018, 102, 6279–6298. [Google Scholar] [CrossRef]
- Du, F.Y.; Li, X.M.; Zhang, P.; Li, C.S.; Wang, B.G. Cyclodepsipeptides and other O-containing heterocyclic metabolites from Beauveria felina EN-135, a marine-derived entomopathogenic fungus. Mar. Drugs 2014, 12, 2816–2826. [Google Scholar] [CrossRef]
- Krug, J.C.; Benny, G.L.; Keller, H.W. 21—Coprophilous Fungi. In Biodiversity of Fungi; Mueller, G.M., Bills, G.F., Foster, M.S., Eds.; Academic Press: Burlington, MA, USA, 2004; pp. 467–499. [Google Scholar] [CrossRef]
- Yu, H.; Sperlich, J.; Höfert, S.P.; Janiak, C.; Teusch, N.; Stuhldreier, F.; Wesselborg, S.; Wang, C.; Kassack, M.U.; Dai, H.; et al. Azaphilone pigments and macrodiolides from the coprophilous fungus Coniella fragariae. Fitoterapia 2019, 137, 104249. [Google Scholar] [CrossRef]
- Del Valle, P.; Figueroa, M.; Mata, R. Phytotoxic eremophilane sesquiterpenes from the coprophilous fungus Penicillium sp. G1-a14. J. Nat. Prod. 2015, 78, 339–342. [Google Scholar] [CrossRef] [PubMed]
- Jayanetti, D.R.; Li, Y.; Bartholomeusz, G.A.; Bills, G.F.; Gloer, J.B. Benzophenone and fimetarone derivatives from the coprophilous fungus Delitschia confertaspora. J. Nat. Prod. 2017, 80, 707–712. [Google Scholar] [CrossRef]
- Yu, X.; Müller, W.E.G.; Guo, Z.; Lin, W.; Zou, K.; Liu, Z.; Proksch, P. Indole alkaloids from the coprophilous fungus Aphanoascus fulvescens. Fitoterapia 2019, 136, 104168. [Google Scholar] [CrossRef] [PubMed]
- Wu, C.; Chen, Y.; Huang, X.; Sun, S.; Luo, J.; Lu, Z.; Wang, W.; Ma, Y. An efficient shortened genetic transformation strategy for filamentous fungus Trichoderma reesei. J. Gen. Appl. Microbiol. 2020, 65, 301–307. [Google Scholar] [CrossRef]
- Hooykaas, P.J.J.; van Heusden, G.P.H.; Niu, X.; Reza Roushan, M.; Soltani, J.; Zhang, X.; van der Zaal, B.J. Agrobacterium-mediated transformation of yeast and fungi. Curr. Top. Microbiol. Immunol. 2018, 418, 349–374. [Google Scholar] [CrossRef] [PubMed]
- Timberlake, W.E.; Marshall, M.A. Genetic engineering of filamentous fungi. Science 1989, 244, 1313–1317. [Google Scholar] [CrossRef] [PubMed]
- Zhang, Z.F.; Liu, F.; Zhou, X.; Liu, X.Z.; Liu, S.J.; Cai, L. Culturable mycobiota from karst caves in China, with descriptions of 20 new species. Persoonia 2017, 39, 1–31. [Google Scholar] [CrossRef] [PubMed]
- Xu, L.; Li, Y.; Biggins, J.B.; Bowman, B.R.; Verdine, G.L.; Gloer, J.B.; Alspaugh, J.A.; Bills, G.F. Identification of cyclosporin C from Amphichorda felina using a Cryptococcus neoformans differential temperature sensitivity assay. Appl. Microbiol. Biotechnol. 2018, 102, 2337–2350. [Google Scholar] [CrossRef]
- Langenfeld, A.; Blond, A.; Gueye, S.; Herson, P.; Nay, B.; Dupont, J.; Prado, S. Insecticidal cyclodepsipeptides from Beauveria felina. J. Nat. Prod. 2011, 74, 825–830. [Google Scholar] [CrossRef]
- Chung, Y.M.; El-Shazly, M.; Chuang, D.W.; Hwang, T.L.; Asai, T.; Oshima, Y.; Ashour, M.L.; Wu, Y.C.; Chang, F.R. Suberoylanilide hydroxamic acid, a histone deacetylase inhibitor, induces the production of anti-inflammatory cyclodepsipeptides from Beauveria felina. J. Nat. Prod. 2013, 76, 1260–1266. [Google Scholar] [CrossRef]
- Zhang, P.; Zhou, S.; Wang, G.; An, Z.; Liu, X.; Li, K.; Yin, W.B. Two transcription factors cooperatively regulate DHN melanin biosynthesis and development in Pestalotiopsis fici. Mol. Microbiol. 2019, 112, 649–666. [Google Scholar] [CrossRef]
- Yelton, M.M.; Hamer, J.E.; Timberlake, W.E. Transformation of Aspergillus nidulans by using a trpC plasmid. Proc. Natl. Acad. Sci. USA. 1984, 81, 1470–1474. [Google Scholar] [CrossRef]
- Yu, J.H.; Hamari, Z.; Han, K.H.; Seo, J.A.; Reyes-Dominguez, Y.; Scazzocchio, C. Double-joint PCR: A PCR-based molecular tool for gene manipulations in filamentous fungi. Fungal Genet. Biol. 2004, 41, 973–981. [Google Scholar] [CrossRef] [PubMed]
- Wang, X.; Wu, F.; Liu, L.; Liu, X.; Che, Y.; Keller, N.P.; Guo, L.; Yin, W.B. The bZIP transcription factor PfZipA regulates secondary metabolism and oxidative stress response in the plant endophytic fungus Pestalotiopsis fici. Fungal Genet. Biol. 2015, 81, 221–228. [Google Scholar] [CrossRef] [PubMed]
- Wu, J.D.; Chou, J.C. Optimization of protoplast preparation and regeneration of a medicinal fungus Antrodia cinnamomea. Mycobiology 2019, 47, 483–493. [Google Scholar] [CrossRef]
- Ma, Z.; Liu, J.; Lin, X.; Shentu, X.; Bian, Y.; Yu, X. Formation, regeneration, and transformation of protoplasts of Streptomyces diastatochromogenes 1628. Folia Microbiol. 2014, 59, 93–97. [Google Scholar] [CrossRef] [PubMed]
- Liu, T.H.; Lin, M.J.; Ko, W.H. Factors affecting protoplast formation by Rhizoctonia solani. New Biotechnol. 2010, 27, 64–69. [Google Scholar] [CrossRef]
- Ning, P.; Liang, P.; Xiang, N.; Zheng, Y.; Xiao, Y.N. Preparation and regeneration of protoplasts of Sporisorium reilianum f. Hubei Agric. Sci. 2012, 51, 4520–4523. [Google Scholar] [CrossRef]
- Pannunzio, N.R.; Watanabe, G.; Lieber, M.R. Nonhomologous DNA end-joining for repair of DNA double-strand breaks. J. Biol. Chem. 2018, 293, 10512–10523. [Google Scholar] [CrossRef]
- Rehman, L.; Su, X.; Guo, H.; Qi, X.; Cheng, H. Protoplast transformation as a potential platform for exploring gene function in Verticillium dahliae. BMC Biotechnol. 2016, 16, 57. [Google Scholar] [CrossRef]
- Idnurm, A.; Walton, F.J.; Floyd, A.; Reedy, J.L.; Heitman, J. Identification of ENA1 as a virulence gene of the human pathogenic fungus Cryptococcus neoformans through signature-tagged insertional mutagenesis. Eukaryot. Cell 2009, 8, 315–326. [Google Scholar] [CrossRef] [PubMed]
- Walton, F.J.; Idnurm, A.; Heitman, J. Novel gene functions required for melanization of the human pathogen Cryptococcus neoformans. Mol. Microbiol. 2005, 57, 1381–1396. [Google Scholar] [CrossRef]
- Idnurm, A.; Reedy, J.L.; Nussbaum, J.C.; Heitman, J. Cryptococcus neoformans virulence gene discovery through insertional mutagenesis. Eukaryot. Cell 2004, 3, 420–429. [Google Scholar] [CrossRef]
- Bailey, C.R.; Butler, M.J.; Normansell, I.D.; Rowlands, R.T.; Winstanley, D.J.J.B. Cloning a Streptomyces clavuligerus genetic locus involved in clavulanic acid biosynthesis. Nat. Biotechnol. 1984, 2, 808–811. [Google Scholar] [CrossRef]
- Yu, J.; Zhang, Y.; Cui, H.; Hu, P.; Yu, X.; Ye, Z. An efficient genetic manipulation protocol for Ustilago esculenta. FEMS Microbiol. Lett. 2015, 362, fnv087. [Google Scholar] [CrossRef] [PubMed]
- van Hartingsveldt, W.; Mattern, I.E.; van Zeijl, C.M.; Pouwels, P.H.; van den Hondel, C.A.; MGG, G.G. Development of a homologous transformation system for Aspergillus niger based on the pyrG gene. Mol. Genet. Genom. 1987, 206, 71–75. [Google Scholar] [CrossRef]
- Ying, S.H.; Feng, M.G.; Keyhani, N.O. Use of uridine auxotrophy (ura3) for markerless transformation of the mycoinsecticide Beauveria bassiana. Appl. Microbiol. Biotechnol. 2013, 97, 3017–3025. [Google Scholar] [CrossRef]
- Ballance, D.J.; Turner, G. Development of a high-frequency transforming vector for Aspergillus nidulans. Gene 1985, 36, 321–331. [Google Scholar] [CrossRef]
- Jun-Tian, L.I.; Xiao-Li, F.U.; Ying, Z.; Qi, W.; Pei-Ji, Z. Two cyclopeptides from endophytic fungus Beauveria sp.Lr89 isolated from maytenus hookeri. Nat. Prod. Res. Dev. 2011, 23, 667–669. [Google Scholar] [CrossRef]
- Li, D.; Tang, Y.; Lin, J.; Cai, W. Methods for genetic transformation of filamentous fungi. Microb. Cell Factories 2017, 16, 168. [Google Scholar] [CrossRef]

| Strain/Plasmid | Description | Reference |
|---|---|---|
| A. guana LC5815 | Wild type (WT, CGMCC 3.17908) | [16] |
| pAG1-H3 | Hygromycin resistance vector | [20] |
| TYML6 | ΔAG04914::hph in WT | This study |
| TYML7 | ΔAG04326::hph in WT | This study |
| Primers | Oligonucleotide Sequence (5′-3′) | Uses |
|---|---|---|
| HYG_F | atcgatgatcaggcctcgac | Maker hygromycin amplification |
| HYG_R | gtgcattctgggtaaacgactc | Maker hygromycin amplification |
| HYG_RT_R | ccgagagctgcatcaggtc | ΔAG04914 transformant 5F screening |
| HYG_RT_F | gcgaagcagaagaatagcttagc | ΔAG04914 transformant 3F screening |
| KO04326-5F-F | gtgcatcgcagcgattgatg | Up flanks’ amplification for AG04326 deletion |
| KO04326-5F-nest | cgccaggctaatgcactatg | Diagnostic PCR for AG04326 deletion |
| KO04326-5F-R | cactcatcacagcttgtcgatcccgatgctgaatcggtag | Up flanks’ amplification for AG04326 deletion |
| KO04326-3F-F | cgattcagcaatcgggatcgacaagctgtgatgagtgcag | Down flanks’ amplification for AG04326 deletion |
| AGpyrG-3F-R-nest | ctggtagttgaaggtggtcagg | Diagnostic PCR for AG04326 deletion |
| AGpyrG-3F-R | gtacttgagcgcctcgaactc | Down flanks’ amplification for AG04326 deletion |
| C35-04914-5F-F | ccgaattgaccaggtgcttc | ΔAG04914 transformant 5F screening |
| C35-04914-5F-nest | ggccagtcgtacttgtagacg | knockout AG04914 cassette |
| C35-04914-5F-R | gtcgtttacccagaatgcacggatcacaccgagaagagcag | knockout AG04914 cassette |
| C35-04914-3F-F | gtcgaggcctgatcatcgatcggatctcctcagtacatggc | knockout AG04914 cassette |
| C35-04914-3F-nest | gcctctgttgttgccattgtc | knockout AG04914 cassette |
| C35-04914-3F-R | gatctctccgctgaggaacag | ΔAG04914 transformant 3F screening |
Publisher’s Note: MDPI stays neutral with regard to jurisdictional claims in published maps and institutional affiliations. |
© 2021 by the authors. Licensee MDPI, Basel, Switzerland. This article is an open access article distributed under the terms and conditions of the Creative Commons Attribution (CC BY) license (http://creativecommons.org/licenses/by/4.0/).
Share and Cite
Liang, M.; Li, W.; Qi, L.; Chen, G.; Cai, L.; Yin, W.-B. Establishment of a Genetic Transformation System in Guanophilic Fungus Amphichorda guana. J. Fungi 2021, 7, 138. https://doi.org/10.3390/jof7020138
Liang M, Li W, Qi L, Chen G, Cai L, Yin W-B. Establishment of a Genetic Transformation System in Guanophilic Fungus Amphichorda guana. Journal of Fungi. 2021; 7(2):138. https://doi.org/10.3390/jof7020138
Chicago/Turabian StyleLiang, Min, Wei Li, Landa Qi, Guocan Chen, Lei Cai, and Wen-Bing Yin. 2021. "Establishment of a Genetic Transformation System in Guanophilic Fungus Amphichorda guana" Journal of Fungi 7, no. 2: 138. https://doi.org/10.3390/jof7020138
APA StyleLiang, M., Li, W., Qi, L., Chen, G., Cai, L., & Yin, W.-B. (2021). Establishment of a Genetic Transformation System in Guanophilic Fungus Amphichorda guana. Journal of Fungi, 7(2), 138. https://doi.org/10.3390/jof7020138

